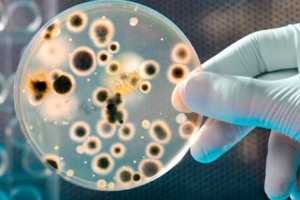
трихомониаз симптомы

Трихомониаз – преимущественно мужское половое инфекционное заболевание, возбудителем которого является простейшая одноклеточная трихомонада.
Главная опасность болезни заключается в ее скудной симптоматике, поэтому у большинства людей, обращающихся за помощью к венерологам, трихомониаз выявляют уже на достаточно серьезной стадии, когда он чем-нибудь осложняется или переходит в хроническую форму.
При этом, своевременно предпринятое лечение в кратчайшие сроки избавляет человека от этой неприятной болезни. У прекрасной половины человечества трихомониаз локализуется во влагалище, у мужчин же в предстательной железе и мочеиспускательном канале.
Как передается?
Наиболее распространенным способом проникновения трихомонад в организм людей является половой контакт. Однако это не единственный способ, существуют и другие пути, по которым инфекция достигает половых органов людей.
- Вертикальная передача. Речь идет о родах, причем наибольший риск такого заражения приходится именно на девочек.
- Через биологическую жидкость. Имеется ввиду непосредственный контакт с различного рода биологическими жидкостями больного человека (сперма, кровь, слюни и так далее). Поэтому даже обычный поцелуй может стать причиной трихомониаза.
- Через бытовые предметы. Данный вид инфекции может свободно существовать во внешней среде на протяжении как минимум 2-х часов. Поэтому заразиться можно даже через крышку унитаза в общественном туалете. Но чаще это случается при использовании здоровым человеком нижнего белья больного или предметов личной гигиены (полотенца, халата и так далее).
Касательно заражения половым путем стоит добавить только то, что под «половым путем» подразумевается не только генитальный способ передачи, но и генитально-оральный и генитально-анальный. Во всех этих случаях существует огромный риск заполучить от больного человека трихомонад.
Врачи отмечают, что трихомониаз является одной из наиболее распространенных инфекций, передающихся половым путем. Симптомы заболевания могут варьироваться от легких до выраженных. У женщин это может проявляться в виде вагинального зуда, жжения, необычных выделений и болей при мочеиспускании. У мужчин симптомы часто менее заметны, но могут включать зуд в области полового члена и выделения из уретры.
Специалисты подчеркивают важность своевременной диагностики и лечения, так как трихомониаз может привести к серьезным осложнениям, включая воспалительные заболевания органов малого таза. В качестве лечения врачи рекомендуют применение антибиотиков, таких как метронидазол или тинидазол, которые эффективно устраняют инфекцию. Также важно, чтобы оба партнера прошли лечение, чтобы избежать повторного заражения. Регулярные медицинские осмотры и использование средств защиты помогут снизить риск заражения и распространения инфекции.

Симптомы у женщин
Сразу стоит отметить, что трихомониаз у женщин имеет специфические симптомы, поэтому их мы рассмотрим отдельно. Вот наиболее характерные для данного заболевания признаки у женщин:
- Слизистые выделения из влагалища (подобное явление наблюдается в 75% случаев);
- Пенистые или водянистые выделения из влагалища с разительным запахом рыбы;
- Отечность или покраснение гениталий;
- Кровоизлияния;
- Изъязвления на половых губах;
Цвет выделений может меняться от белого до желто-зеленого. Выделениям практически всегда сопутствует зуд, распространяющийся по половым губам и прилежащей к ним области (иногда локализация зуда доходит до внутренней поверхности бедер). В особенно тяжелых случаях зуд осложняется изъязвлениями и небольшими кровотечениями.
Нередко женщины жалуются на болевые ощущения, обычно на жжение в процессе полового акта и мочеиспускание. Если инфекция проникает во влагалище, то ко всем вышеописанным симптомам трихомониаза добавляется еще и тянущая боль снизу живота.
В тех случаях, когда трихомонады проникают в мочевой пузырь, признаки болезни расширяются за счет частичной дисфункции данного органа (частые позывы к мочеиспусканию, боль во время мочеиспускания и так далее).
Симптомы у мужчин
В отличие от женщин, у сильной половины человечества симптомов трихомониаза или вообще нет, или они проявляются незначительно, в этом и заключается главная его опасность для мужчин. Кроме того, бессимптомное течение болезни может привести к развитию простатита, способного вызывать бесплодие. Причем в данном случае речь идет не только о простатите, но об простатите, осложненном трихомониазом.
В таких случаях инфекция (имеется в виду трихомонады) размножающаяся в семенной жидкости мужчин продуцирует специфические продукты жизнедеятельности, обездвиживающие и затормаживающие рост сперматозоидов. Но и самое главное – отсутствие симптомов болезни не означает, что мужчина не может ее передать другому человеку.
Говоря о том, какие трихомониаз имеет симптомы у мужчин, стоит начать с самого важного и характерного признака заболевания – выделений из уретры. Они могут быть гнойными, кровавыми и белыми пенистыми. При мочеиспускании у большинства представителей сильной половины человечества наблюдается также жжение и резь.
С развитием заболевания эти симптомы расширяются за счет глубинной тазовой боли или рези (изредка жжения), а также постоянного чувства дискомфорта. Нередко трихомониаз у мужчин осложняется уретритом (воспалительный процесс в уретре), но это уже в более запущенных случаях. Если вовремя не начать лечение уретрита болезнь может привести к сужению уретры.
В острой форме заболевание проявляется лишь на протяжении первых нескольких недель, затем симптоматика либо вообще исчезает, либо в существенной степени ослабевает, что уже свидетельствует о том, что трихомониаз находится на стадии перехода к хронической форме.
Трихомониаз — это инфекция, вызываемая простейшим организмом Trichomonas vaginalis, и многие люди сталкиваются с его симптомами, которые могут варьироваться от легкого дискомфорта до более серьезных проявлений. Чаще всего пациенты отмечают зуд, жжение, а также необычные выделения из половых органов. Некоторые могут не испытывать никаких симптомов, что затрудняет диагностику и лечение.
Мнения о методах лечения трихомониаза также разнообразны. Врачебные рекомендации обычно включают применение антибиотиков, таких как метронидазол или тинидазол, которые эффективно устраняют инфекцию. Однако важно помнить, что лечение должно проходить под контролем специалиста, так как самолечение может привести к осложнениям. Многие пациенты подчеркивают важность своевременной диагностики и регулярных обследований, чтобы избежать повторного заражения и защитить партнеров.

Лечение
Сразу стоит отметить, что лечение производится независимо от того, имеет ли заболевание явные симптомы или нет. Все лечебные мероприятия осуществляются не только в отношении больного, но и в отношении его половых партнеров (иногда членов семьи). Лечение половых партнеров производится даже в тех случаях, когда анализы дают отрицательный результат. Все дело в том, что иммунная система людей крайне неустойчива к данной инфекции, а потому возможно повторное заражение, которое лечением врачи и пытаются предотвратить.
Средняя длительность лечебных мероприятий составляет 1-2 недели. Однако при наличии осложнений или хронической формы болезни этот срок может увеличиваться.
Среди основных лекарственных препаратов для приема внутрь стоит отметить метронидазол, орнидазол, тенидазол и прочие. В дополнении к этому практически всегда врачи предписывают кремы наподобие Розекса и Розамета для внешнего применения.
Иногда вышеописанную методику усиливают за счет препаратов местного действия (в их составе имеется метронидазол). Но в таких случаях больных обязывают отказаться от употребления спиртных напитков на время лечения и еще на 30 дней после его окончания.
Если говорить о том, как лечить трихомониаз в хронической его форме или при наличии осложнений, то тут все немного иначе. Врачи индивидуально подбирают препараты иммунокорректоры и иммуностимуляторы и дополняют ими основное лечение, которое также усиливают за счет макролида кларитромицина (увеличивает антибактериальный эффект).
Для защиты печени применяют гепатопротекторы наподобие Легалона. Во всех остальных случаях терапия симптоматическая. Речь идет о приеме обезболивающих препаратов для устранения жжения и болевого синдрома, о физиотерапии и прочих методах.
Примерно через 6-7 дней после полного окончания лечения производят контрольные исследования, по результатам которых врач определят здоров пациент или требуется дополнительная терапия.
Профилактика
Любой вид полового акта должен проходить в презервативе. Причем очень важно обрабатывать половые органы местными антисептиками наподобие мирамистина при нарушении целостности презерватива в процессе полового акта. Также рекомендуется хотя бы раз в полгода или раз в год проходить стандартное профилактическое обследование в поликлинике по месту прописки. Соблюдение этих элементарных правил в большинстве случаев препятствует проникновению в организм человека инфекции трихомониаза.

Вопрос-ответ
Чем лучше всего лечить трихомониаз?
Лечение трихомониаза поддается терапии и может быть полностью излечено. Лучше всего для лечения данной инфекции подходят антибиотики метронидазол или тинидазол.
Какой антибиотик убивает трихомонаду?
Трихомониаз обычно быстро и легко лечится антибиотиками. Большинству людей назначают антибиотик под названием метронидазол, который очень эффективен, если принимать его правильно. Обычно вам придется принимать метронидазол два раза в день в течение 5–7 дней. Иногда этот антибиотик можно назначать в виде одной, большей дозы.
Какие симптомы трихомонады могут быть у женщин?
Симптомы трихомониаза у женщин: выделения из влагалища зеленоватого или желтоватого цвета с неприятным запахом. Выделения могут быть пенистыми или водянистыми. Жжение и зуд в области влагалища и наружных половых органов. Боль или дискомфорт во время мочеиспускания и полового акта.
Советы
СОВЕТ №1
Регулярно проходите медицинские обследования. Трихомониаз может протекать бессимптомно, поэтому важно регулярно проверяться у врача, особенно если у вас есть рискованные факторы, такие как смена половых партнеров.
СОВЕТ №2
Обратите внимание на симптомы. Если вы заметили необычные выделения, зуд или дискомфорт в области половых органов, не откладывайте визит к врачу. Раннее выявление и лечение помогут избежать осложнений.
СОВЕТ №3
Следуйте рекомендациям врача по лечению. Трихомониаз обычно лечится антибиотиками, и важно завершить полный курс лечения, даже если симптомы исчезли. Это поможет предотвратить рецидив и распространение инфекции.
СОВЕТ №4
Используйте защитные средства. Презервативы могут значительно снизить риск передачи трихомониаза и других инфекций, передающихся половым путем. Это особенно важно при наличии нескольких половых партнеров.